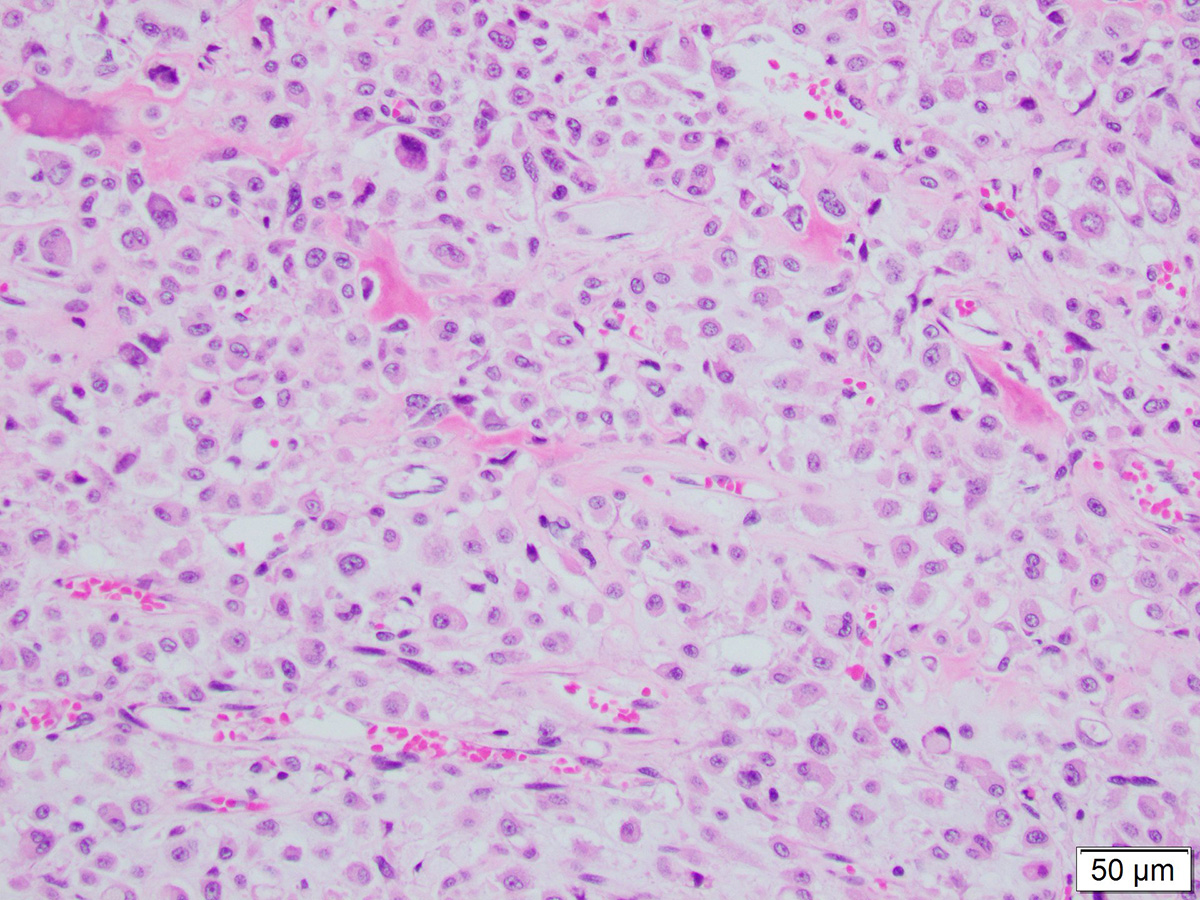

Case of the Month: Femoral Head Lesion
Case Authors: Hatice Betul Zengin, MD (PGY-2), Tatsiana Pukhalskaya, MD (PGY-4), Xi Wang, MD
Clinical History
A middle aged male presented with several month history of pain and swelling of his hip.
Past Medical History
No significant past medical history.
Recent History
MRI of the left hip showed a lobular subcortical lesion encompassing the majority of the femoral head. It demonstrated a predominantly low signal intensity on T1 weighted images, with high signal intensity on T2 weighted lesions, with areas of lower signal intensity (both T1 and T2) throughout (Figure 1).
Arthroplasty was performed. Gross examination of the submitted specimen revealed a 4.6 x 4.4 x 4 cm yellow and white variegated mass within the trabecular bone of the femoral head. Histological examination of representative sections revealed infiltrating tumor cells with cartilaginous background. Several patterns of the tumor were identified (Figures 2-4).